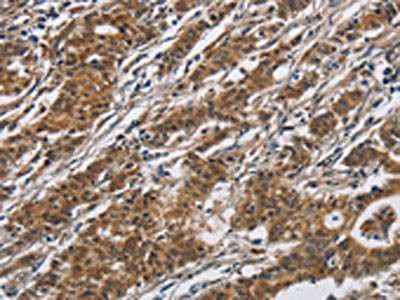

DHRS3 Antibody
-
中文名稱:DHRS3兔多克隆抗體
-
貨號:CSB-PA283024
-
規格:¥1100
-
圖片:
-
The image on the left is immunohistochemistry of paraffin-embedded Human breast cancer tissue using CSB-PA283024(DHRS3 Antibody) at dilution 1/30, on the right is treated with fusion protein. (Original magnification: ×200)
-
The image on the left is immunohistochemistry of paraffin-embedded Human gastric cancer tissue using CSB-PA283024(DHRS3 Antibody) at dilution 1/30, on the right is treated with fusion protein. (Original magnification: ×200)
-
Gel: 10%SDS-PAGE, Lysate: 40 μg, Lane 1-2: Mouse liver tissue, A375 cells, Primary antibody: CSB-PA283024(DHRS3 Antibody) at dilution 1/550, Secondary antibody: Goat anti rabbit IgG at 1/8000 dilution, Exposure time: 20 seconds
-
-
其他:
產品詳情
-
Uniprot No.:
-
基因名:DHRS3
-
別名:DHRS3; RDH17; SDR16C1; UNQ2424/PRO4983; Short-chain dehydrogenase/reductase 3; DD83.1; Retinal short-chain dehydrogenase/reductase 1; retSDR1; Retinol dehydrogenase 17; Short chain dehydrogenase/reductase family 16C member 1
-
宿主:Rabbit
-
反應種屬:Human,Mouse
-
免疫原:Fusion protein of Human DHRS3
-
免疫原種屬:Homo sapiens (Human)
-
標記方式:Non-conjugated
-
抗體亞型:IgG
-
純化方式:Antigen affinity purification
-
濃度:It differs from different batches. Please contact us to confirm it.
-
保存緩沖液:-20°C, pH7.4 PBS, 0.05% NaN3, 40% Glycerol
-
產品提供形式:Liquid
-
應用范圍:ELISA,WB,IHC
-
推薦稀釋比:
Application Recommended Dilution ELISA 1:2000-1:5000 WB 1:500-1:2000 IHC 1:50-1:200 -
Protocols:
-
儲存條件:Upon receipt, store at -20°C or -80°C. Avoid repeated freeze.
-
貨期:Basically, we can dispatch the products out in 1-3 working days after receiving your orders. Delivery time maybe differs from different purchasing way or location, please kindly consult your local distributors for specific delivery time.
-
用途:For Research Use Only. Not for use in diagnostic or therapeutic procedures.
相關產品
靶點詳情
-
功能:Catalyzes the reduction of all-trans-retinal to all-trans-retinol in the presence of NADPH.
-
基因功能參考文獻:
- Yap targets Dhrs3, to reduce retinoic acid synthesis and inhibit cardiac fibroblast differentiation during development. PMID: 29689192
- Mouse Dhrs3 plays critical roles in the development of the heart by controlling the formation of retinoic acid. PMID: 29447006
- The retinaldehyde reductase DHRS3 is essential for preventing the formation of excess retinoic acid during mouse embryonic development PMID: 24005908
- we proposed that four newly identified peripheral blood mononuclear cells-derived genes( DHRS3, TTC38, SAP30BP and LPIN2 )could be integrated with previously reported rheumatoid arthritis (RA)-associated genes to monitor and/or diagnose RA. PMID: 28371410
- the bifunctional nature of retinoid oxidoreductase complex provides the RA-based signaling system with robustness by safeguarding appropriate RA concentration despite naturally occurring fluctuations in RDH10 and DHRS3. PMID: 28232491
- Data indicate that retinaldehyde reductase (DHRS3) requires retinol dehydrogenase 10 (RDH10) for full enzymatic activity and, in turn, activates RDH10. PMID: 24733397
- p53-Inducible DHRS3 is an endoplasmic reticulum protein associated with lipid droplet accumulation. PMID: 21659514
- The retSDR1 is identified as novel transcriptional target of the p53 family and not transactivated by EEC syndrome-specific mutations of TAp63gamma. PMID: 20543567
- CST6, CXCL14, DHRS3, and SPP1 are regulated by BRAF signaling and may play a role in papillary thyroid carcinoma pathogenesis PMID: 18676742
顯示更多
收起更多
-
亞細胞定位:Membrane; Multi-pass membrane protein.
-
蛋白家族:Short-chain dehydrogenases/reductases (SDR) family
-
組織特異性:Widely expressed with highest levels found in heart, placenta, lung, liver, kidney, pancreas, thyroid, testis, stomach, trachea and spinal cord. Lower levels found in skeletal muscle, intestine and lymph node. No expression detected in brain. In the retin
-
數據庫鏈接:
Most popular with customers
-
-
YWHAB Recombinant Monoclonal Antibody
Applications: ELISA, WB, IHC, IF, FC
Species Reactivity: Human, Mouse, Rat
-
Phospho-YAP1 (S127) Recombinant Monoclonal Antibody
Applications: ELISA, WB, IHC
Species Reactivity: Human
-
-
-
-
-